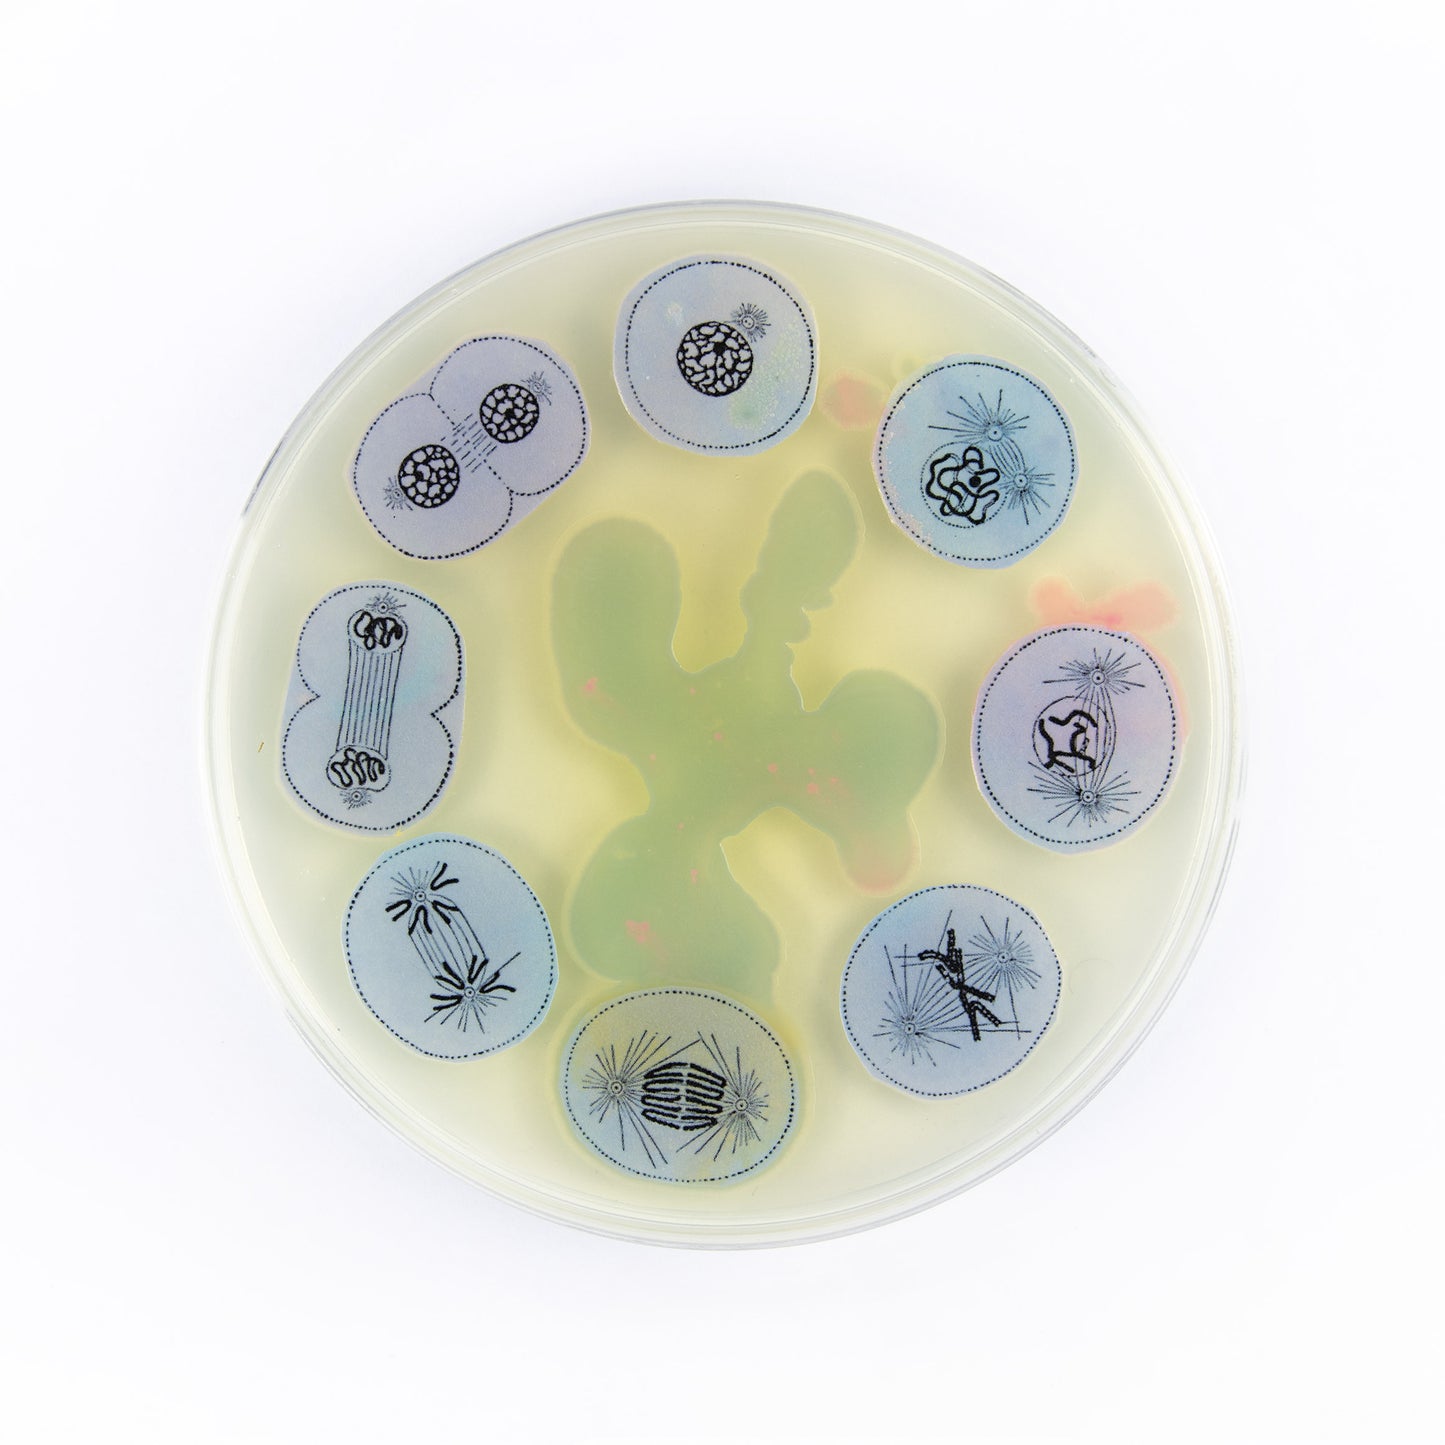
Baroque Biology Petri: Mitosis Dance

Baroque Biology Petri: Mitosis Dance
Couldn't load pickup availability

2020
Printed on Epson Premium Lustre Photopaper 240gsm
Baroque Biology (Paper Theatre) is a series of LB Agar petri dishes containing imaginary biological vignettes where non-human organisms teach humans complex biotechnological processes. Reminiscent of William Hogarth’s serial engravings combined with fairy tales from a biotech future, each allegory focuses on a non-human organism who tries to communicate with humans in a helpful manner about the biological processes they employ for survival, for reproduction, and/or aesthetic pleasure. Sometimes the human characters are open to receiving the communicated information, and sometimes they are hostile, or ignorant to the messages they are receiving across species. This work is inspired by Lynn Margalius and Dorion Sagan who argue that humans learned genetic engineering from microorganisms, and Bruno Latour who argues that Pasteur collaborated with microorganisms in the discovery of penicillin. These perspectives upset the more common biotech narrative of human ingenuity and discovery as the central force in advancing biotechnological research.Each vignette is staged within the context of a paper theatre collage. Petri dishes growing GMO bacteria also contain paper cut outs, gold leaf, and 3D sculptural agar forms. The dished are incubated and photographed after the bacteria have time to interact with the print components.
Share

Shipping & Returns
General Shipping:
IOTA Studios offers free shipping on all orders over $100 within Canada, with the exception of framed artworks and sculptures.
International shipping rates are calculated upon checkout.
Packages are shipped by Canada Post.
Depending on size, prints are wrapped in with a stiffener, sealed in a plastic and shipped flat or carefully rolled in a sturdy box.
In the description of each artwork, it is specified whether it is digitally signed or hand signed.
Please reach out to iotastudiogallery@gmail.com for any specific shipping and handling questions. Orders ship within 10 business days.
Returns
If you have any issues with your artwork acquisition please email us at iotastudiogallery@gmail.com. We do not accept returns or exchanges. If your works arrive damaged, please notify us with images of the artwork within 14 days of delivery. Damaged digital prints will be replaced at the cost of IOTA, and in the case that a unique and irreplaceable artwork is damaged, IOTA will lead a claim process with shippers and the client will be offered a store credit or refund for the value of the artwork.
Public Display
Artwork purchased through IOTA Studio Gallery is not for public display. Canadian Artists' Representation/Le Front des artistes canadiens (CARFAC) sets presentation standards for Canadian artists, which require that artists be paid equitably for their work, including exhibitions. If the artwork is to be displayed publicly, or in an exhibition, IOTA Studios or the artist must be contacted directly to discuss presentation fees for the artist.



